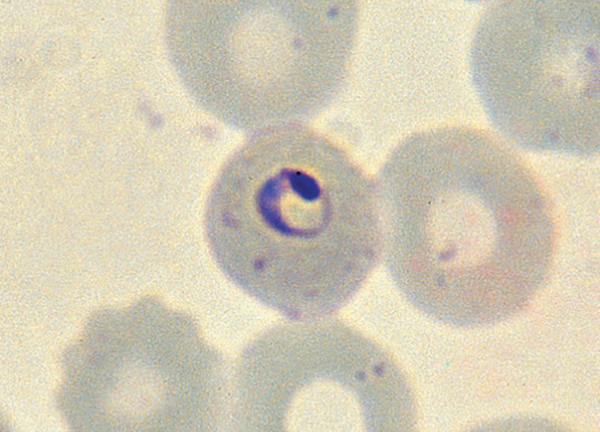
マラリア
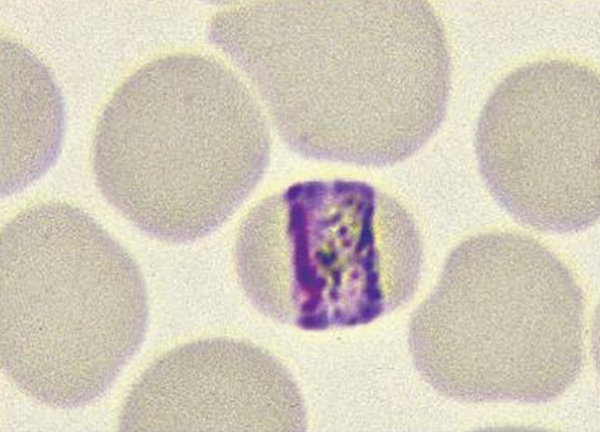
マラリア

GMSニュースレター
今、話題になっている世界の熱帯医学、渡航医学、感染症の
ニュース&トピックスをピックアップしてお届けします!
【GMS.eラーニング】マラリアクイズ BASIC
GMSニュースレターでは、eラーニングの一部を無料公開していきます。
「マラリアクイズBASIC」は、マラリア原虫の顕微鏡での特徴をクイズ形式で解説します。典型例を分かりやすく原虫別に出題していきます。これらの画像は、「マヒドン大学熱帯医学部出版(英語)の寄生虫アトラス」から抜粋したものと、実際の顕微鏡の画像を混在して入れています。実臨床では教科書画像のように分かりやすい画像とは限らないので、注意が必要です。※「GMS.eラーニング」は、会員限定のコンテンツとなります。GMS会員登録後「GMS.eラーニング」へのご招待メールをお送りさせていただきます。
※GMS会員登録で、マヒドン大学熱帯医学部出版(英語)の寄生虫アトラス(Atlas of Medical Parasitology※左図参照)が500円引になります。
【Vol.1】マラリアの種類、特徴、感染ステージをお答えください。
<クイズ解答>P. falciparum 熱帯熱マラリアRing form stage (Early trophozoite)P. falciparumのRing formは、細胞質が薄いのが特徴です。Double infection, double chromatinも見えます。典型的なP. falciparumの所見です。出典:Atlas of Medical Parasitology
【Vol.2】マラリアの種類、特徴、感染ステージをお答えください。
<クイズ解答>P. falciparum 熱帯熱マラリアGrowing trophozoite。見る機会の少ないP. falciparumのGrowing trophozoite stageです。感染赤血球は大きくなく、少ないですがMaurer’s dotsも見られます。出典:Atlas of Medical Parasitology



 【Vol.3】タイ西部の田舎で子供の便のスクリーニングを行いました。8歳の男児、便のスメアで左記の像が顕微鏡で見えました。特に症状はありません。寄生虫の種類を同定してください。
【Vol.3】タイ西部の田舎で子供の便のスクリーニングを行いました。8歳の男児、便のスメアで左記の像が顕微鏡で見えました。特に症状はありません。寄生虫の種類を同定してください。
<クイズ解答>回虫 Ascaris lumbricoides 最も大きい線虫感染症です。世界中で10億人を超える感染者がいると推測されています。ヒトが固有宿主 defenitive hostです。サイズが大きいため、沢山感染することで腸閉塞を起こしたりすることがあります。成虫は小腸に寄生します。感染性のある卵を摂取後幼虫は小腸でふ化、門脈→肝→右心→肺→気管→咽頭→小腸に達します。感染から成虫になるまで2-3ヵ月、寿命は1年程度。
成熟した雌の回虫は1日20万個の卵を産卵します。多数の卵を産卵するため感染していれば便中に容易に卵を見つけることができます。多くのhelminthsの卵は一般的に3層で、中間層にキチンが含まれており卵の構造の維持に重要な働きをします。https://www.cdc.gov/parasites/ascariasis/biology.html
 【Vol.4】60歳男性。タイ、ミャンマー沿いの森林地帯で生活をしています。発熱、黄疸があり、診療所を受診しました。
【Vol.4】60歳男性。タイ、ミャンマー沿いの森林地帯で生活をしています。発熱、黄疸があり、診療所を受診しました。
血液のスメアにて左の所見を認めました。マラリアの種類、特徴、感染ステージをお答えください。
<クイズ解答>P. vivax 三日熱マラリア
ステージ:Growing trophozoite stage
感染赤血球が大きいこと。Schuffner‘s dotsがあることからP. vivaxと診断がつきます。
2つ原虫が見えるためDouble infectionと診断します。この原虫の細胞質は大きくないので、Growing trophozoiteと判断しました。
 【Vol.5】タイ西部の田舎で子供の便のスクリーニングを行いました。
【Vol.5】タイ西部の田舎で子供の便のスクリーニングを行いました。
6歳の女児、便のスメアで左記の像が顕微鏡で見えました。
軽度の貧血を認めます。寄生虫の種類を同定してください。
<クイズ解答>鉤虫 Hookworm Ancylostoma spp.
Necator americanus
Hookworm egg 60-70×40μm Oval shape.
Colorless thin transparent egg shell. 4 cells inside
雌は1日あたり数千から数万個産卵します。
多数の卵を産卵するため感染していれば便中に容易に卵を見つけることができます。
【Vol.6】このマラリアの種類、特徴、感染ステージをお答えください。
【Vol.6】このマラリアの種類、特徴、感染ステージをお答えください。
<クイズ解答>P.vivax もしくは P.ovale Ring form(Early trophozoite)Shuffner’s dots様に見えます。感染赤血球は大きくなく、細胞質のやや肉厚なRing formが見えます。StageはRing form (Early Trophozoite)です。
Ring form stageだと、赤血球は形は大きくないことがあり、またDotsもはっきりしません。Shuffner’s dotsがあるので、P. vivax もしくはP. ovaleと推測します。
このマラリア原虫は実はP. ovaleになります。
Ring formが一つだけ見える場合は、血液像を隈なく流し、他のマラリア原虫を見つけて種を確定する必要があります。
【Vol.7】
【Vol.7】
このマラリアの種類、特徴、感染ステージをお答えください。
<クイズ解答>
P.malariae 四日熱マラリア
Growing Trophozoite (Band form)
感染赤血球が大きくないこと。Dotsがないこと。
特徴的なBand formの所見からP.malariaeと診断がつきます。
 【Vol.31】
【Vol.31】
このマラリアの種類、特徴、感染ステージをお答えください。
<クイズ解答>P. malariae 四日熱マラリア
Late schizont (Rosette formation)
まず赤血球が見えないのでこれはThick smearです。
Thick smearでは種の同定はできないので、この後Thin smearで確定をします。Chromationと細胞質の色の違いに注意下さい。
Chromation が多数(8つ以内)見えるのでSchizont stageです。
メロゾイトの数自体では種の同定はできませんが、マラリアpigmentを取り囲むようにしてメロゾイトが見えます。
特徴的なRosette formationですので、P. malariaeと推測します。
| P. falciparum | 熱帯熱マラリア | 8-32 | 16 |
| P. vivax | 三日熱マラリア | 12-18 | 16 |
| P. ovale | 卵形マラリア | 6-12 | 8 |
| P. malariae | 四日熱マラリア | 6-12 | 8 |
 【Vol.32】
【Vol.32】
このマラリアの種類、特徴、感染ステージをお答えください。
<クイズ解答>P. falciparum 熱帯熱マラリア
Early Trophozoite(Ring form)
まず赤血球が見えないのでこれはThick smearです。Thick smearでは種の同定はできないので、この後Thin smearで確定をします。Chromationと細胞質の色の違いに注意下さい。細胞質の大きさがクロマチンと比べあまり大きくないこと、Ring様に見えます。Early trophozoite stageです。
種の同定はできませんが、多数のRing formのみ見えることからP. falciparumと推測します。
 【Vol.33】
【Vol.33】
このマラリアの種類、特徴、感染ステージをお答えください。
<クイズ解答>P. vivax 三日熱マラリア
まず赤血球が見えないのでこれはThick smearです。Thick smearでは種の同定はできないので、この後Thin smearで確定をします。
Chromationと細胞質の色の違いに注意下さい。
青矢印:細胞質の大きさがクロマチンと比べあまり大きくないこと、Ring様に見えます。Early trophozoite stageです。
オレンジ矢印:細胞質がクロマチンよりも大きく見えます。Growing trophozoite stageです。
赤矢印:クロマチン自体が多いく細胞質も大きく見えます。Late trophozoite stageです。
 【Vol.34】
【Vol.34】
このマラリアの種類、特徴、感染ステージをお答えください。
<クイズ解答>P. falciparum 熱帯熱マラリア
Ring form (Early trophozoite), Mature schizont Thin smearです。
Ring formはすぐわかると思います。Ring formだけは種の同定ができないため、その横のSchizontで鑑別を考えます。白血球かマラリアを鑑別する点としては、茶色のマラリアピグメント(青矢印)、Dots(黄矢印)です。
感染赤血球は周囲の赤血球と比べて大きくありません。
Dotsは大きく、数が少ないのでMaurer’s dotsです。
紫の●一つ一つ(赤矢印)がMerozoiteです。
Merozoiteは20以上あり、以上を併せてP. falciparumとの診断になります。
| P. falciparum | 熱帯熱マラリア | 8-32 | 16 |
| P. vivax | 三日熱マラリア | 12-18 | 16 |
| P. ovale | 卵形マラリア | 6-12 | 8 |
| P. malariae | 四日熱マラリア | 6-12 | 8 |
【寄生虫クイズ】
 【Vol.35】
【Vol.35】
35歳男性 インドから帰国後水溶性下痢が続いている。便の顕微鏡の検査にて写真の病原体がみられた。診断は何でしょうか。
<クイズ解答>Entamoeba coli cyst(非病原性アメーバ)
消化管原虫のCystです。病原性、非病原性アメーバの鑑別のためにはまず大きさの評価を行います。消化管原虫は×400で評価をします。7目盛り×2.5= 17.5μmとなります。E. histolytica(赤痢アメーバ)のcystは15μmを超えることはあまりなく、E. histolyticaにしては大きい印象です。
また内部の核の数を数えると5つ以上見えます。E. histolyticaの核は4つ以上見えることはありません。以上からアメーバは、E. coliで非病原性のアメーバと診断されます。下痢は別の原因検索が必要です。
| Amoebae | Nuclei Number | Trophozoite(µm) | Cyst(µm) | Average(µm) | |
| Big | ・Entamoeba histolytica / dispar | 4 | 15-50 | 10-35 | 15 |
| Middle | ・Entamoeba coli | 8 | 10-60 | 10-20 | 12 |
| Small | ・Entamoeba hartmanni | 4 | 5-12 | 5-10 | <10 |
| Small | ・Entamoeba nana | 4 | 6-12 | 5-10 | <10 |
| Small | ・Lodamoeba butschill | 1 | 8-20 | 5-20 | <10 |